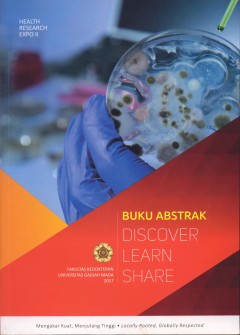
cover

Ditapis dengan

Jejak Diplomasi Retno Marsudi Tegas dalam Prinsip, Lentur dalam Cara: Kilas B…
Buku ini terdiri atas sepuluh bab yang mendalami dan komprehensif, menyajikan kisah-kisah penting dan strategi diplomaso yang diimplementasikan oleh Retno Marsudi saat menjabat sebagai Menteri Luar Negri
- Edisi
- -
- ISBN/ISSN
- 6786231607201
- Deskripsi Fisik
- xiv + 266 hlm., 15cm x 23 cm
- Judul Seri
- -
- No. Panggil
- 320.9598 BJO j

Anatomi Fisiologi & Biokimia Keperawatan
Layaknya manusia yang saling membantu agar tetap hidup, ilmu biologi dan ilmu lainnya dapat saling menolong agar menghasilkan pengetahuan yang bermanfaat bagi kehidupan. Pemahaman yang baik tentang ilmu biologi memungkinkan pemberian pelayanan keperawatan yang cepat dan tepat. Pembahasan lebih lanjut tentang ilmu biologi dasar dan perkembangan, khususnya dalam bidang kesehatan (keperawatan), d…
- Edisi
- Cet. 1
- ISBN/ISSN
- 9786020874562
- Deskripsi Fisik
- 240 hlm; 15 x 23 cm
- Judul Seri
- -
- No. Panggil
- 612 ANA a
E-book The Curry Secret : Indian Restaurant Cookery at Home
Many difficulties stand in the way of anyone trying to explore the secrets of Indian cooking. People buy a cookbook but find the traditional recipes and methods can be disappointing when they produce a home cooked taste and not the distinct flavour of their favourite restaurant curries. This is not really surprising, as the art of restaurant cooking is a very closely kept secret, next to imposs…
- Edisi
- -
- ISBN/ISSN
- 9780716020547
- Deskripsi Fisik
- 91 hlm
- Judul Seri
- -
- No. Panggil
- 641.554 DHI t
E-book Perspectives on Science and Culture
The application of rhetorical and narrative approaches to science have been used to analyze the discourse of popular culture and how it relates to complex social phenomena such as the proliferation of pseudoscience or antipsychiatry. The rhet-oric of science studies how scientists—as part of a discursive community—frame and communicate their knowledge; what they argue about and how…
- Edisi
- -
- ISBN/ISSN
- 9781612495217
- Deskripsi Fisik
- 309 hlm
- Judul Seri
- -
- No. Panggil
- 801 RUT p
Buku Abstrak Discover, Learn, Share Health Research Expo
Kumpulan Abstrak Penelitian dari Health Research Expo II Fakultas Kedokteran Universitas Gadjah Mada.
- Edisi
- -
- ISBN/ISSN
- -
- Deskripsi Fisik
- xviii+350 hlm.18x25 cm
- Judul Seri
- -
- No. Panggil
- 610.5 FAK b
 Karya Umum
Karya Umum  Filsafat
Filsafat  Agama
Agama  Ilmu-ilmu Sosial
Ilmu-ilmu Sosial  Bahasa
Bahasa  Ilmu-ilmu Murni
Ilmu-ilmu Murni  Ilmu-ilmu Terapan
Ilmu-ilmu Terapan  Kesenian, Hiburan, dan Olahraga
Kesenian, Hiburan, dan Olahraga  Kesusastraan
Kesusastraan  Geografi dan Sejarah
Geografi dan Sejarah